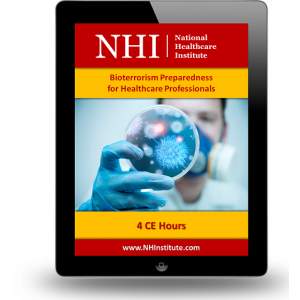

- Home
- About Us
- CE Accreditation
-
CE Courses
- Nursing CE Courses
- Advanced Nursing Practice
- Critical Care Nursing
- Disaster and Terrorism Management
- Emergency Nursing
- Ethics, Legal and Advocacy
- Infection Control and Community Nursing
- Gerontology
- Leadership and Management
- Medical-Surgical Nursing
- Nursing Sciences
- Nursing Skills and Procedures
- Pediatric Nursing
- Perioperative Nursing
- Pharmacology
- Psychiatric / Mental Health
- State-Required Courses
- Teaching and Preceptorship
- CE Course Bundles
- Medical CME Courses
- Inservice Courses
- Nursing CE Courses
- CE Certification
- Resources
- FAQ
- Contact Us